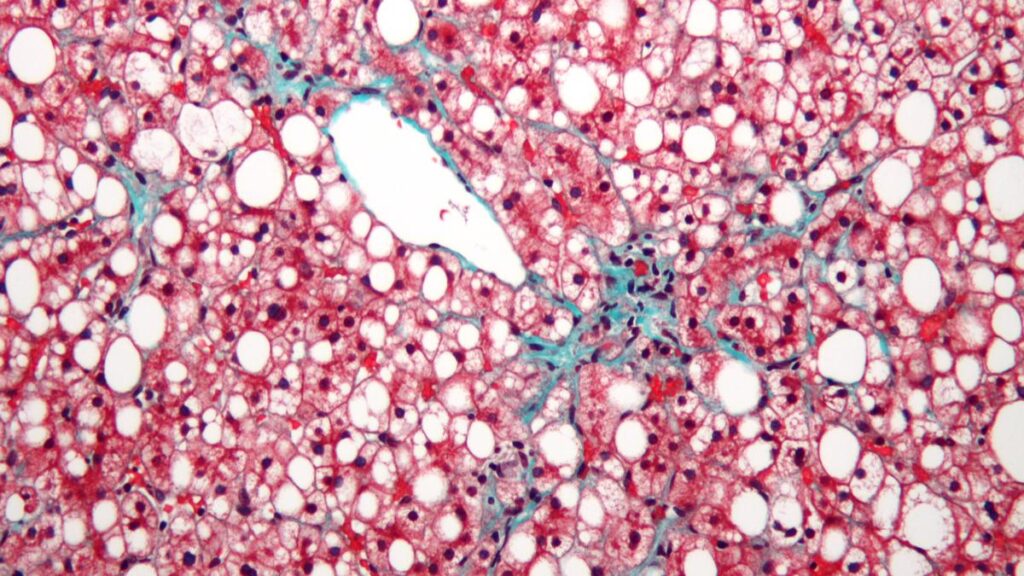
The urgent need to combat the epidemic of fatty liver in India

970x125
Fatty liver disease is rising in India at an alarming rate. The new terminology coined in 2023 for fatty liver disease is Steatotic Liver Disease. Over the past five years, various studies have shown that 35–40% of the Indian adult population is affected — and this is a conservative estimate. What’s even more worrying is that children are not exempt. Research indicates that around 35% of Indian children have fatty liver disease. When we combine the numbers for both children and adults, it is estimated that 40–50 crore people in India are currently affected. This is a staggering figure, given our total population, and highlights the urgency of the situation.
970x125
Fatty liver is not just a standalone condition—it often serves as a warning sign or co-presenter of other major diseases such as obesity, diabetes, heart disease, kidney disease, stroke, and even cancers. Individuals with fatty liver have a significantly higher predisposition to these conditions as well. If left unaddressed, fatty liver could snowball into a major national health crisis, leading to complications such as liver cirrhosis, liver cancer, and serious metabolic diseases. We must act now with public awareness, lifestyle interventions, and early screening to curb this growing epidemic.
Fatty liver occurrence
Fatty liver literally means excess fat getting deposited in the liver. As this fat builds up, the liver starts swelling and, over time, loses its ability to function properly, leading to various health problems. The main cause is a mismatch between the calories we consume and the calories we burn. When we eat more fatty and calorie-dense foods — such as processed foods, red meat, fried items, and foods rich in oil — and do not burn enough calories through physical activity, the excess calories are converted to fat and this begins to accumulated in the liver.
Today’s eating habits often include high amounts of processed and fatty foods, combined with low physical activity. This unhealthy combination results in a steady increase of fat storage in the liver.
Initially, fat deposits in the liver may be small and harmless, but if unhealthy habits persist, these deposits gradually accumulate to dangerous levels, resulting in fatty liver disease. The main contributors to this condition are an unhealthy diet, a sedentary lifestyle, and consuming more calories than the body burns. To prevent and even potentially reverse fatty liver disease, a comprehensive lifestyle modification that focuses on both diet and physical activity is essential.

Risk factors
Is fatty liver only seen in obese individuals?No. Although obesity is a major risk factor, the condition can also occur in people with normal body weight, a condition often referred to as lean fatty liver. This can develop due to a variety of reasons, including metabolic factors such as insulin resistance, type 2 diabetes, high cholesterol, hypertension, and metabolic syndrome. A genetic predisposition, such as family history or certain genetic variations, can also play a role.
Dietary and lifestyle habits, including high consumption of sugars, refined carbohydrates, transfats, alcohol, and lack of physical activity, contribute significantly as well. In addition, hormonal and medical conditions like hypothyroidism, polycystic ovary syndrome (PCOS), and Cushing’s syndrome are known causes. Some medications, including corticosteroids, tamoxifen, methotrexate, amiodarone, and valproate, may also induce fatty liver. Nutritional issues such as severe malnutrition or rapid weight loss, as well as gut-related factors like an altered gut microbiome or small intestinal bacterial overgrowth (SIBO), can further increase the risk of developing the disease.
In fact, lean fatty liver can sometimes be more insidious because it is less suspected clinically but still carries the risk of progression to inflammation, fibrosis, cirrhosis, and even liver cancer. Thus, fatty liver is not just a disease of obesity—it is a multifactorial metabolic and systemic condition that requires careful evaluation of underlying causes.

The new terminology
In general the term is SLD (Steatotic Liver Disease), which is an umbrella term which addresses any reason for fatty liver. The term NAFLD (Non-Alcoholic Fatty Liver Disease) has recently been replaced to better reflect the disease spectrum and underlying causes. For people with obesity or metabolic disease it is called MASLD (Metabolic dysfunction-Associated Steatotic Liver Disease).
Prevention
Fatty liver can be prevented right from the start with proper diet control and healthy lifestyle changes.
Maintaining liver health begins with eating a balanced diet that includes adequate proteins, moderate amounts of healthy carbohydrates, and minimal unhealthy fats, while also incorporating plenty of vegetables, fruits, whole grains, and nuts. Regular physical activity is equally important: engaging in activities such as walking, jogging, cycling, or sports for at least 40 to 45 minutes a day five days a week can make a significant difference.
For those with diabetes, keeping blood sugar under control through proper diet, exercise, and medical guidance is crucial. Similarly, managing high cholesterol with lifestyle changes, medications if prescribed, and regular medical follow-ups helps protect the liver. Achieving and maintaining an ideal body weight is one of the most effective ways to reverse fatty liver, with at least a 10% reduction in body weight being strongly recommended for those affected.
By being careful with food choices, staying active, and managing underlying health conditions, fatty liver can be completely prevented.
Also Read:Reduction of fat in liver lowers risk of Non-Alcoholic Fatty Liver Disease: UoH study
Detection
Detecting fatty liver requires effort from our side. Most cases are discovered by chance during a routine health check, because in the early stages, fatty liver usually produces no symptoms. However, once it progresses to high-grade fatty liver, fibrosis, or cirrhosis, symptoms may begin to appear — often when significant liver damage has already occurred. This highlights the importance of preventive health checks.
People who are at higher risk, such as those who are obese, have high cholesterol, or are diabetic, should regularly monitor their liver health to rule out fatty liver disease. This can be done through simple and effective detection methods. An abdominal ultrasound can help in detecting and grading fatty liver. Liver function tests (LFT) are useful in identifying any damage or abnormal functioning caused by fatty deposits in the liver. More advanced options like transient elastography or non-invasive ultrasound-based tests not only quantify the extent of fatty liver but also detect fibrosis, making them highly valuable tools in deciding the appropriate course of treatment.
We should not wait for fatty liver to cause symptoms. Regular, proactive screening is our responsibility — allowing early detection and timely treatment to prevent complications.
Also Read:Kerala to set up fatty liver clinics in district hospitals
Appropriate management
Once fatty liver is diagnosed, treatment should start without delay, even at Grade 1. Since most cases are identified at Grade 1 or Grade 2, the focus at these stages is primarily on lifestyle and dietary changes. Regular physical activity and avoiding prolonged sedentary habits play a crucial role in management. A balanced diet with high protein intake, moderate carbohydrates, limited unhealthy fats, and plenty of vegetables, fruits, and nuts is strongly recommended. It is equally important to keep diabetes, cholesterol, and blood pressure under good control, as these conditions often coexist with fatty liver. Achieving and maintaining an ideal body weight is essential, with scientific evidence showing that weight reduction is the most effective way to reverse fatty liver. A minimum of 10% weight loss is advised for anyone diagnosed with the condition.

Are medicines needed?
Contrary to popular belief, the decision to begin medication for fatty liver is not determined by the grade shown on an ultrasound report. Instead, it depends on several key factors, including the presence of fibrosis, abnormalities in liver function tests, coexisting conditions such as diabetes or high cholesterol, and the need to address obesity with medication. With the availability of newer drugs designed specifically for fatty liver and the wider metabolic syndrome involving diabetes, cholesterol, and obesity, treatment can now be personalised to suit each individual’s health profile.

Do not ignore
Fatty liver may appear to be a harmless condition at the beginning, but if ignored, it can progress into serious and potentially life-threatening complications. Without timely intervention, fatty liver can advance from inflammation of the liver, known as hepatitis, to the development of scar tissue called fibrosis, and eventually to cirrhosis, which causes permanent and irreversible damage to the liver. Cirrhosis is a severe stage of liver disease in which the organ can no longer carry out its vital functions effectively. When the disease reaches advanced stages, the only available treatment may be a liver transplant, which is a highly complex and major procedure.

The good news
Fatty liver in its early stages is reversible with proper treatment and lifestyle changes. That’s why early detection and management are critical.
It is important to keep a regular check on your liver health instead of waiting for symptoms to appear. Taking timely action with the right treatment according to the stage of fatty liver can help prevent its progression and reduce the risk of reaching irreversible damage. Protecting your liver today is the key to ensuring a longer and healthy life.
(Dr. P. Senthilnathan is a surgical gastroenterologist & director, GEM Hospital, Chennai. directorchennai@geminstitute.in)
970x125